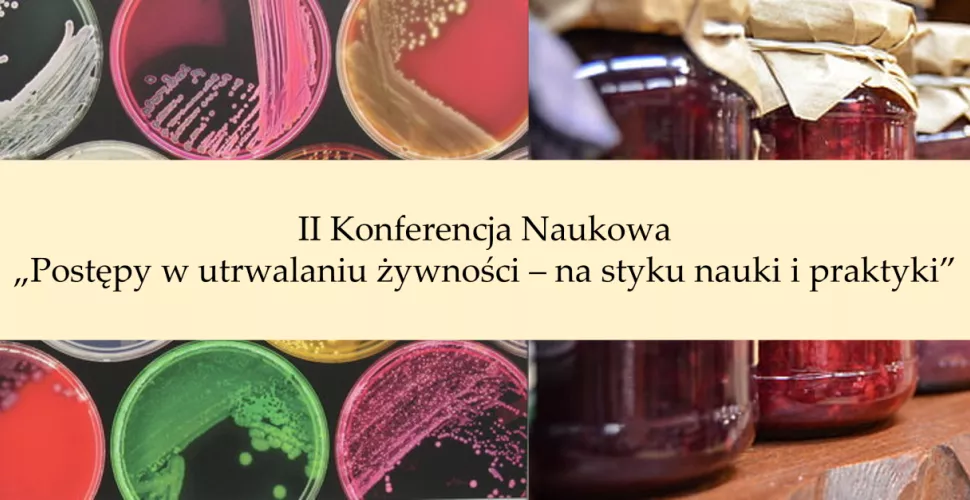
Kolorowe szalki z mikroorganizmami i słoiki

W imieniu Komitetu Naukowego oraz Organizacyjnego mamy zaszczyt zaprosić Państwa na II Konferencję Naukową „Postępy w utrwalaniu żywności – na styku nauki i praktyki”, organizowaną przez Instytut Technologii Fermentacji i Mikrobiologii Politechniki Łódzkiej oraz Komitet Nauk o Żywności i Żywieniu PAN, która odbędzie się w Łodzi w dniu 7 września 2023 r. Patronat nad konferencją obejmą: JM Rektor Politechniki Łódzkiej, Polskie Towarzystwo Technologów Żywności oraz portal informacyjny FoodFakty.
Organizatorzy
Patronat nad wydarzeniem obejmą:
Celem konferencji jest wymiana wiedzy na temat utrwalania żywności w aspekcie jej bezpieczeństwa, innowacyjnych narzędzi w technologiach i metodach badawczych oraz wymiana doświadczeń pomiędzy naukowcami i przedstawicielami branży spożywczej. Konferencja będzie doskonałą platformą nawiązania współpracy na styku nauki i przemysłu oraz tworzenia nowoczesnych rozwiązań w odpowiedzi na aktualne zagadnienia utrwalania i bezpieczeństwa żywności.
Tematyka konferencji obejmuje:
1. Bezpieczeństwo żywności pochodzenia roślinnego i zwierzęcego
2. Systemowe podejście do bezpieczeństwa żywności
3. Funkcjonalne dodatki do żywności
4. Metody analizy jakości i bezpieczeństwa żywności
W trakcie konferencji przewidziane są wykłady plenarne, wystąpienia ustne oraz sesja posterowa. Dodatkowo planowana jest Sesja Młodych Naukowców Fresh&Foodie, której celem jest zaprezentowanie osiągnięć młodych adeptów nauki, możliwość owocnej dyskusji oraz integracji. Dla autorów wyróżnionych doniesień konferencyjnych planowane są nagrody.
Uczestnicy będą mieli możliwość opublikowania swoich prac naukowych w formie rozdziału w recenzowanej monografii naukowej, która zostanie wydana nakładem Wydawnictwa Politechniki Łódzkiej (rozdział – 20 pkt. MEiN). Po publikacji prace będą także dostępne w formie open access na stronie internetowej konferencji.